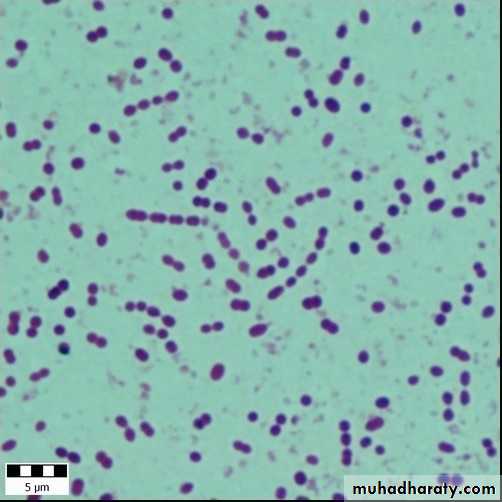
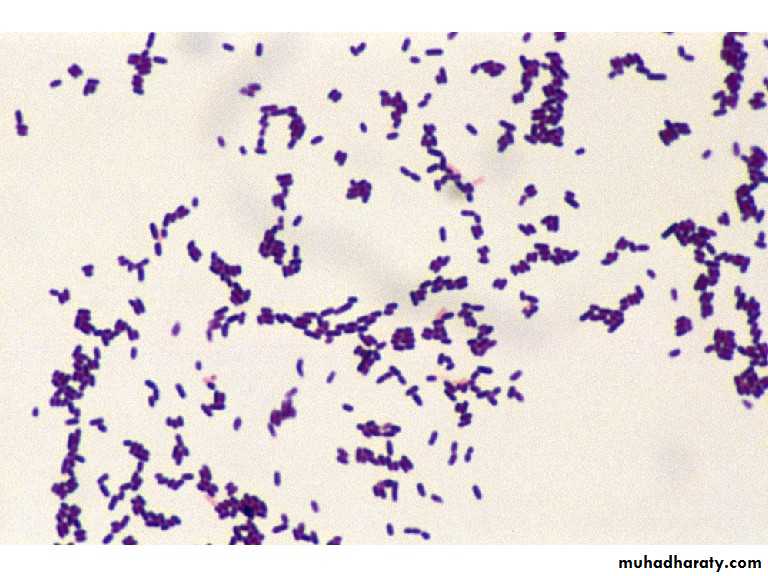

Intracranial infection
ObjectivesTo know about clinical presentation of meningitis and Encephalitis
To know about the common infective organisms responsible meningitis and encephalitis.
To know about the pathophysiology of meningitis and Encephalitis
To know how to investigate a patient suspected of intracranial infection
To know the main differential diagnosis of meningitis and of encephalitis
To know about empirical treatment of meningitis and encephalitis
To know about complications of meningitis and Encephalitis
Sites
MeningitisEncephalitis
Parameningeal: sinusitis, mastoiditis, otitis media, brain abscess, spinal epidural abscess.
Presentation
FeverHeadache
Vomiting
. Neck pain and signs of meningeal irritation.
+?
Disturbed consciousness
Seizures
Focal neurological manifestations
+?
Manifestations of the causative agent.
Pathophysiology
Inflammation -> fibrinous exudate -> fibrosis
Subpial Encephalopathy
Increase intracranial pressure
Brain Oedema -> herniation
Vasculitis -> infarcts
Venous sinus thrombosis
Hydrocephalus
Encephalitis -> Direct dysfunction of areas of brain
Ventriculitis
Cortical Infarcts
Inflammation around vessels
Subpial Encephalopathy
Inflammation of Cranials
Atiology
Infective- Bacterial -> Acute: Pneumo, Meningo, H.Inf, List.mono
Subacute: TB, Ricketseal, Brucellosis
-Viral: H.simplex, V.Z, E.Bar, JC, etc..
-Fungal
Non infective -> Connective Tissue
Malig: fixed, Leuk, Lymph
Radiation, Chemeical
Aetiology
According to Age:
CSF changes
CSF appearance
Analysis
Other CSF parameters
ManometryGram stain
Sereological
Procalcitonin
PCR
Cases
10 years old boy presented with fever headache, photophobia and vomiting of 3 days duration, was very toxic, history of similar condition in his brother was noted, which lead to death. O/E Neck stiffness and Kernig’s sign were positive. CSF: protein 120 mg/dl, sugar 39 mg/dl (blood 99 mg/dl), cells: 600 WBC, 90% Neutrophils. Gram stain shown below, also picture of his brother’s condition is shown below:
What is the most likely pathogen?
Cases
5 years old boy presented with fever headache and vomiting of 3 days duration, O/E Neck stiffness and Kernig’s sign were positive. CSF: protein 120 mg/dl, sugar 39 mg/dl (blood 99 mg/dl), cells: 600 WBC, 90% Neutrophils. Gram stain shown below:What is the most likely pathogen?
Cases
35 years old man known thalasemic presented with fever headache and vomiting of 3 days duration, O/E Neck stiffness and Kernig’s sign were positive. CSF: protein 200 mg/dl, sugar 39 mg/dl (blood 99 mg/dl), cells: 2600 WBC, 90% Neutrophils. Had a history of splenctomy 1 year ago. Gram stain shown below:What is the most likely pathogen?
Cases
30 years old pregnant lady with fever headache and vomiting of 5 days duration, with acute onset deterioration in level of consciousnss following a complaint of double vision.O/E Neck stiffness and Kernig’s sign were positive. Bilateral VI, and spastic quadriparesis. CSF: protein 200 mg/dl, sugar 39 mg/dl (blood 99 mg/dl), cells: 300 WBC, 90% Neutrophils.
What is the most likely pathogen?
Cases
17 years old girl brought to A&E with severe agitation and speaking non sense, sustained three fits each preceded by abnormal sense of smell for few seconds. O/E there was mild neck stiffness, Kernig sign was negative. However she was Dilerious. CSF showed protein 67 mg/dl, sugar normal, cells 10 WBC, all lymphocytes. Gram stain negative.EEG reveals bilateral temporal spikes and MRI picture shown below. What is the diagnosis:Differential Diagnosis
Meningitis:-Subarachoid Hemorrhage
-Venous Sinus Thrombosis
Encephalitis
Encephalitis
Venous Infarction
Hemorrhagive Leucoencphalitis
Meningitis
Investigations
CBC & ESR, U&E, LFT, Nasopharyngeal swab, Blood cultures
CXR
CT scan & MRI brain , also for sinuses, otitis media, and other parameningeal source.
EEG
MRV & MRI
Tuberculin test
HIV screen
Management
Steroids
Pyogenic Meningitis: Dexamethason: 4mg q6h iv x 4dHerpes Simplex encephalitis: Dexamethason 8mg q12h x 4d
TB: 8mg iv q12h x 20 days
Antimicrobial therapy
Antimicrobial therapy
SpecificOf meningococcal M. Prophylaxis
Households, close contact (children)Rifampicine: po q12h x2d
<1 year -> 5mg/kg/dose
>1 year -> 10mg/kg/dose
Adult: 600mg/dose
OR
Single dose Ciprofloxacin 500mg
Complications
HydrocephalusCranial nn palsies
Stroke
Dementia
Amnesia
Aphasias
Venous sinus thrombosis
Death